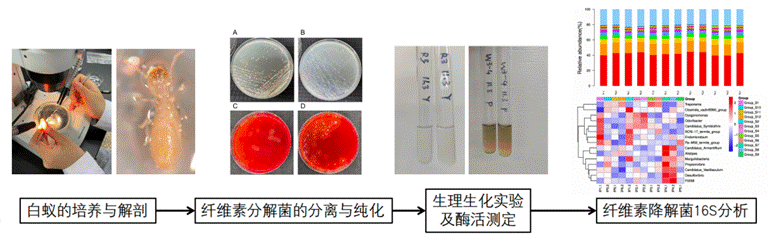

项目名称:白蚁肠道纤维素降解菌的多样性研究及快速降解秸秆复合菌群的构建
团队成员:房映旭、王琛、肖欣、陈皞楠、靳智超
指导教师:李佛生、曹毅
项目简介:
我国木质纤维素资源丰富,产量巨大,但以秸秆为主的纤维素材料具有分解困难和处理时间长等缺点,限制了其降解与综合利用,本项目通过白蚁匀浆液分离出纤维素分解菌与固氮菌,并建立复合菌系,为微生物促秸秆还田及纤维素综合利用探索一条新道路。本实验从黑胸散白蚁体表与肠道分离到纤维素分解菌45株,筛选高纤维素酶活菌株10株,筛选高活力半纤维素分解菌、木质素分解菌和固氮菌各3株,分离所得纤维素分解菌主要为粘质沙雷氏菌属、柠檬酸杆菌属、蜡样芽孢杆菌属与已有文献报道白蚁肠道存在的Trabulsiella属。本项目构建纤维素分解菌与固氮菌复合发酵菌系,结果表明,在本实验的培养条件下,单一纤维素分解菌发酵体系中,单一种固氮菌存在与两种固氮菌存在的情况体系总纤维素分解酶酶活均提高;两种不同属纤维素分解菌存在的发酵体系中,单一种固氮菌与两种固氮菌的存在均降低了体系总纤维素分解酶酶活。

图1 项目技术路线图
图2 项目主要内容展示

图3 白蚁解剖过程展示